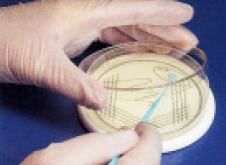
Cpsulas de Petri, plantilla para

Cargando, por favor espere ...

Plantilla para Cápsulas de Petri
Compuesto por un pack que contiene dos soportes:
G-PLATE 1: para enrasar de Agar la cápsula de Petri.
G-PLATE 2: plantilla para ayudar al aislamiento de una cepa bacteriana.
| Código | Descripción | Cantidad |
| 2004GPLATE | Plantilla para Cápsulas de Petri | 1 |
| Código | Descripción | Disponibilidad | Precio (€) | Cantidad | Añadir |
|---|---|---|---|---|---|
| 2004GPLATE | Cápsulas de Petri, plantilla para, Descripción=Plantilla para Cápsulas de Petri | Consultar | Consultar | --- |